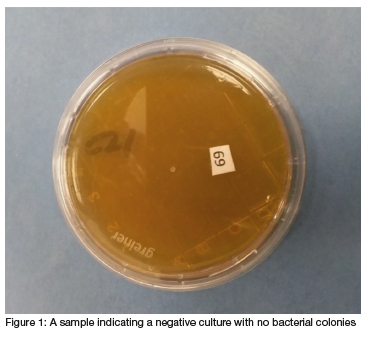
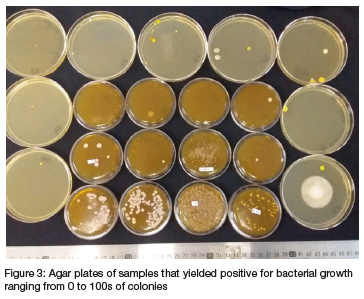
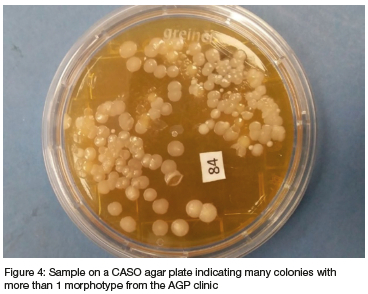

Services on Demand
Journal
Article
Indicators
Related links
-
 Cited by Google
Cited by Google -
 Similars in Google
Similars in Google
Share
South African Dental Journal
On-line version ISSN 0375-1562Print version ISSN 0011-8516
S. Afr. dent. j. vol.78 n.1 Johannesburg Feb. 2023
RESEARCH
Surveillance of specific pathogens on mobile phones in aerosol and non-aerosol generating dental clinics during the COVID pandemic
AB KhanI; E MabozaII; N VallyIII; A TaliepIV
IBChD, PDD, MSc, PhD) Department of Restorative Dentistry, Faculty of Dentistry, University of the Western Cape, S. Africa
IIMSc Department of Research, Faculty of Dentistry, University of the Western Cape
IIIBDS Community Service
IVBDS Community Service
ABSTRACT
Following COVID-19 protocols implemented globally, it is prudent to extend this to mobile phones, regarded as carriers of microbes, as these are used extensively in clinical settings for learning and patient care.
AIM: Was to determine types of microbes harbored on mobile phones and related hygiene practices whilst using these in aerosol and non-aerosol generating dental settings
METHODOLOGY: This cross-sectional study was conducted in two parts: A laboratory study to determine the prevalence of microbes on mobile phones and a questionnaire survey to determine the related knowledge and behavior of phone users in both aerosol and non-aerosol generating dental clinics. All proper protocols (consent, ethics) were adhered to
RESULTS: A small percentage (27.2%) of swabs of mobile phones yielded a positive bacterial culture, of these 72% were from the AGP dental setting. Gram positive and negative microorganisms were distinguishable, indicating a diverse group of microbes. Students and staff indicated good mobile phone hygiene practices, but there is place for improvement. Their related knowledge of disinfectants and use were acceptable, but not having mobile phone coverings was problematic
CONCLUSION: Faculty protocols for disinfecting mobile phones and standardized guidelines for its use in aerosol or non-aerosol clinics is recommended
Keywords: Mobile phones in dental clinics; Pathogens on mobile phones; COVID-19 mobile phone protocols; phone clinical use; phone hygiene practices; mobile phone use guidelines.
INTRODUCTION
Electronic devices, such as mobile phones, smartphones and computers have become a necessary addition to the armamentarium of the public, and in the academic setting where it is considered as essential for students and professionals. With the corona virus disease (COVID-19) pandemic, these devices were seen as a lifeline for daily communiqué and to allow continuance of everyday activities, such as remote working. Thus, it has become an essential part of our lifestyle, impacting greatly on those who use it by keeping them connected to work and loved ones. It was therefore recommended as a tracking device by country health authorities during the current COVID-19 pandemic.1
However, by holding these devices, texting, making calls or reading from it in public and sharing devices between people, germs can be transferred onto and from the mobile phone surfaces.
These mobile phones are appreciated as a necessary form of learning and teaching at tertiary educational institutions.1 These are used to read academic material and do assessments online thus, it must be incorporated as an indispensable tool within the curriculum.1-2 Some benefits identified with mobile phone use in academia include better understanding of students' learning pace, encouraging and empowering more proactive learning, improving conversational skills, and greater academic achievements.1
In the healthcare environment, professionals use these for work-related activities such as: following health-related news; communicating with colleagues and patients; searching databases for updated guidelines, drug interactions, adverse events and health research; taking pictures of patients oral health conditions; sharing of medical documents; conducting tele-consultations as well as patient-tracking and creating appointments.3 The self-reported use of mobile phones among healthcare workers ranges from once in every 15min to once every 2hours.3 Due to its continuous daily use, these devices may be considered as 'hotspots' for carrying and transmission of pathogens, such as corona virus (SARS-COV2).4-6 Mobile phones are thus highly touched surfaces and should be cleansed daily to avoid transmission of identified and unidentified pathogens.2,5,7
Constant and widespread use of mobile phones leads to a build-up of pathogenic microbes on the surfaces and can lead to infection and transmission of various diseases.2 Electronic devices in use heat-up and it's this increase in temperatures that create a favorable environment for microbial growth and survival. In addition, disinfection and regular cleaning of mobile phone surfaces was not common among users at the start of the pandemic, where it's reported that 72% of users never washed or cleansed their devices.2 Hence mobile phones act as the perfect fomite, meaning a non-living object possessing the ability to transmit infectious microbes across devices and surfaces.2
The SARS-COV2 viruses and their variants are transmitted via aerosols, stay on different surfaces (including that of electronic devices) for varied lengths of time (hours and days) and at different locations such as hospitals and may be transferred to people who after surface contact then touch their face, mouth, nose and eyes.8,9 It thus has the potential to be one of those microbes being transmitted across surfaces including those of electronic devices.8 Therefore, a person may carry the pathogen on their mobile device and accidentally infect self and others.
Olsen et al., 2020 has identified several groups of microbes (bacterial, viral and fungal types) in different healthcare settings and on hands of individuals.2 In this same study, where both the public and healthcare target groups were investigated, the findings demonstrated that 7 different microorganisms remained consistent on the surfaces of mobile phones: Escherichia coli, CoNS, Bacillus sp., Klebsiella pneumoniae, Pseudomonas aeruginosa, Staphylococcus aureus, and Methicillin-resistant S. aureus.2 Another study conducted in Akola, India, found similar bacteria, and isolated a few other types too.10 Hospitals became extra cautious during the pandemic and follow proper evidence-based cleansing protocols in all clinics, including special procedures directly related to patients to prohibit the spread of the SARS-COV2 virus between people and surfaces, but the focus has not been on electronic devices.6,11
In the study by Hosseini et al., (2018), they demonstrated that 64% of dental students never disinfected or cleaned their mobile phones.11 Some health departments and electronics manufacturers, such as the Apple device company, in response to inquiries related to disinfecting mobile phones, have provided a few guidelines. They recommended using cleansing agents such as a 70% isopropyl alcohol wipe or Clorox disinfecting wipes on mobile devices and then allowing the surfaces to dry.12-14 The type of disinfectant that should be used must be safe enough to avoid damage to the device and to reduce the toxic effects on the users.15 It could, therefore, be part of a regular daily regimen to clean mobile phones and computers. Recommendations for mobile device hygiene must therefore be shared and more stringently implemented.16 Implementation of this type of protocol will counter the trajectory of aerosols created in dental clinics which contain biological materials such as saliva, blood and microbes which are able to survive for extended periods of time.11
The aim of this surveillance study is therefore to determine prevalence of the different types of microbes/pathogens that are regularly found on mobile, or smartphones used in a dental setting.
MATERIALS AND METHODS
This was a cross-sectional laboratory study and questionnaire survey and related to mobile phones used in the dental setting conducted amongst senior and junior dental students and staff at the University of the Western Cape. Information related to the study was shared with participants and informed consent obtained from the specific cohorts. Due to the 3rd wave of COVID-19 lockdown experienced within the country at the time of this study, data collection was firstly delayed, and when researchers resumed, deviated from the intended protocol by necessity as access to all students were limited due to classes being conducted remotely. For this ongoing study, the 1st data collection stage occurred whilst the city was experiencing winter, where the types of pathogens differ from those found in other seasons. Thus, surveillance of the state of mobile phones regarding types of pathogens was reported as experienced during winter and the 3rd wave of the COVID-19 pandemic only.
Students and staff working in aerosol generating clinics were initially targeted, and their mobile phones swabbed using sterile swabs soaked in hygienic physiological saline. The swabs were rotated over each of the surfaces of mobile phones such as the keys, mouthpiece, and earpiece. These swabs were then transported to the laboratory and were aseptically transferred into appropriate enrichment media, which was then cultured, facilitating DNA or RNA extraction. That is, swabs were vortexed and 100uL was pipetted on to fresh CASO agar plates and these were incubated aerobically at 370C for 48 hours. For the 1st phase of this surveillance study, it was sufficient to assay for the presence or absence of pathogens. The specific pathogens proposed for this mobile phone study belonged to the four primary groups of microbes: Gram positive bacteria, Gram negative bacteria, viruses, and fungi which are grouped below:17-18
Group A: Gram positive bacteria: Methicillin-resistant Staphylococcus aureus (MRSA) and Streptococcus pneumoniae.
Group B: Gram negative bacteria: Salmonellae and Pseudomonas aeruginosa,
Group C: Viruses: Human Papilloma virus (HPV) and Human Simplex virus (HSV)
For this current paper, the presence of the different microbes from Groups A and B are reported.
The different types of pathogens harbored on the mobile phones of participants and used daily in the dental clinic, that showed a positive culture after 24 hours, were then exposed to Gram staining to provide a more descriptive identification of the pathogen from either Groups A and/ or B. These were then viewed under a light microscope and a full description is provided.
For the second part of the study, a self-administered questionnaire was emailed to the same students in 3rd and 5th year and to the staff who consented to swabbing of their mobile phones.19 For section A of the questionnaire, the socio-demographic characteristics (age, gender and profession) of each participant was obtained and for section B, a series of questions were posed which related to the use of mobile phones in clinics, mobile phone disinfecting and hygiene habits pre- and during the COVID-19 pandemic, and lastly transmission of pathogens.20 All protocols related to research were followed for this study and these were linked to the guidelines of the Declaration of Helsinki.19
RESULTS
A protocol was developed and registered with the institutional ethics committee (Registration No: BM21/4/7) but it was not published. Consent was obtained from all participants according to the Declaration of Helsinki for all aspects of this research.19-20
3.1. Swabbing of mobile phones
The total number of mobile phones swabbed for this study (N=92) and included students and staff (N=68) working in aerosol generating (AG) clinics and those (N=24) working in non-aerosol generating (Non-AG) clinics.
3.1.1. Cultured swabs
After careful transfer and storage of swabs, these were vortexed and cultured on media incubated at 370C under aerobic conditions. The swabs were cultured on to fresh CASO agar plates to observe positive bacterial growth. The laboratory technician (EM) completed this phase as a blinded procedure as all swabs were coded using numbers for students and letters for staff. Only the primary reseacher (SK) knew which swab belonged to whom. Twenty five samples turned positive for bacterial cultures within 24 hours of incubation: From the AG groups, 16 students and 2 staff members' and from the non-AG groups, only 4 students and 3 staff members'mobile phone swabs yielded positive bacterial cultures, but each looked very different. This could be due to the AG clinic staff being more conscious of cleansing protocols. An example of a negative and positive bacterial culture from mobile phone swabs is shown in Figure 1 and 2 respectively.

3.1.2. Colony Description
Next, the colonies for each of these positive swabs and cultures were estimated to range from 1 to 100s as these were difficult to count individually due to their arrangement over each other (Figure 3). A distinct difference between positively cultured colonies from the swabs of students working in non-AG clinics were mostly cream to white compared to those working in AG clinics which were white, cream, and yellow in color (Figure 3).
The sizes were measured, where possible, using a digital caliper and a description of some of these according to color, shape, size, elevation and/ or margins included (Figures 3, 4, 5, 6): The sizes in diameter of individual bacteria ranged from 0.5 to 7cm, but most were found to be from 3.5cm and above (Figures 4, 5). Different colony morphotypes were observed even on one culture, where their shapes also went from being well rounded and regular to irregular and crenated margins and the surfaces from smooth, raised or flat and dome shaped to being granular (Figures 4, 5, 6 respectively). These differences were seen amongst the bacterial morphotypes between the AG and non AG clinics (Figures 2, 4, 5, 6).

Moreover, most of these colonies were easily spreadable, some were sticky, others were dry and crumbly and difficult to spread. The spreadability of the colonies and lifting the colony with an inoculating loop made it easy to create smears on the glass slide for the next stage of sample evaluation.
3.1.3. Gram Staining
When more than five colony morphotypes were present, the five most prevalent ones were selected, and smears were made by drying and fixing these onto the glass slide. The smears were stained with the Gram staining procedure during this phase. Otherwise, all colony morphotypes were stained (Figure 7).

3.1.4. Morphology of stained pathogens
The staining procedures of the previous phase assisted to determine whether the colony forming units were Gram-positive or negative and to discern their morphologies, that is, in identifying bacteria according to morphology and extracellular and intracellular structures, taking it closer to definitive identification of bacteria in the colonies observed (Figure 8). The descriptions of the intracellular structures obtained from Gram staining viewed under a light microscope indicated that the Gram-positive cocci form chains whereas the Gram-negative appeared like rods and bacilli distinguishing it from the former. Gram-positive yeast-like microorganisms were also observed (Figure 8).

3.2. Questionnaire Results
Due to the COVID pandemic and country lockdown rules experienced during the 3rd wave, not all students received a questionnaire related to mobile phones. It was decided by the principal investigator to rather administer the questionnaires to only those students and staff who were present and had consented to having their mobile phones swabbed.
3.2.1. Questionnaire response rates Of the 92 students and staff who consented to mobile phone swabbing, and to whom the questionnaire was emailed, the following responses were received:
From the total number of questionnaires administered (N=92), a 53% response rate was achieved. Regarding the responses from participants from the different clinics, a total response rate of 54% from the AG clinics with 54% of students and 55% of staff having returned questionnaires at the time of this analysis. Similarly, for responses from the non AG clinic, a total response rate of 50% was observed, with 44% of students and 67% staff who emailed their questionnaires to the researcher.
3.2.2. Questionnaire responses
The following section focuses on the questions posed to participants, but the responses were grouped and are highlighted under the following themes:
• Behavior regarding mobile phone use in clinics Students indicated that their mobile phones are used daily in clinics to search for information, learning and booking of patients. However, many of them indicated not consciously including a hand hygiene protocol after using their mobile phones in the clinics. And the majority in both AG (80%) and non-AG (77.8%) clinics reported not having special phone coverings for preventing transmission of pathogens (Figure 9). However, 83.3% of participants agreed that the faculty should develop guidelines for phone use in clinics especially during the COVID-19 pandemic (Table 1).

• Disinfectants used on mobile phones
Most students from both AG (80%) and non-AG (77.8%) clinics use 70% alcohol to cleanse their mobile phones (Figure 10). Many of them (56% and 66.7% respectively) do include a personal phone cleansing protocol (Figure 10). However, 93.4% of participants indicated they would appreciate the faculty extend the current COVID-19 protocols to include a mobile phone disinfecting protocol (Table 1).

• Pathogen transmission
As expected, their knowledge related to transmission of microbes between different surfaces, for example, phones and hands and other surfaces, is sound, therefore they started their own special cleansing protocols for phones with appropriate disinfecting solutions. Unfortunately, they have not yet used special coverings on their mobile phones.
DISCUSSION
The mobile phones of most of the students and staff indicated a negative culture for the microbes suspected of being present in the dental setting. There were, however, staff and students (28%) whose mobile phones indicated a positive culture for bacterial microbes within 24 hours of it being cultured, implying that not all participants' mobile phones were clear of any pathogens. Nonetheless, this does not mean they did not institute a cleansing protocol, it does create more questions related to the clinical workspace they find themselves in.9 Transmission of microbes could be from other surfaces, the environment, different dental procedures they busy with, from patients on whom they work and from each other or just the extended time of using their mobile phones.3-6, 9
These outcomes are no different to other studies published on this matter, though a difference was expected due to the strict protocols that most healthcare facilities included during the COVID-19 pandemic the world was experiencing.6, 17 It was also recommended that the COVID-19 protocols should be strictly adhered to within these healthcare settings especially, because that would ensure the safety of all patients, staff and students.16 The results of this study deviated from the literature in that most students in both the AG and non-AG clinics included their own mobile phone cleansing protocols regularly, therefore the number of positive cultures were lower than expected.11
The diversity of the microbes and their presentation, however, were unexpected but this could be purely seasonal, though many different types were seen in other studies too.2,10,17,18
And the students and staff in this study have clearly read the literature related to types of disinfectant to be used that would not damage their mobile phones, as the companies at the start of the pandemic were hesitant to use anything on the surfaces.12-13
Due to these differences, it would be wise to test the acquired samples for a more definitive microbe identification, as this could be an indication of how institutional protocols may have to change. As stated before, seasonal changes could have a bearing on the types of microbes observed in this current study outcome. It would be advisable to swab mobile phones during the summer months to ascertain the types of microbes in our environment. And with the 4th wave of the COVID-19 pandemic experienced and the different strains observed then, this should be the next step including engaging faculty on implementing a change to the previously instituted COVID-19 protocol.
All current cleansing and disinfecting protocols noted, however, a stricter and detailed protocol for mobile phone disinfecting and guidelines for using these phones in the dental clinical setting would ensure greater compliance from students and staff. In fact, it would make patients more aware of the transmission of infections, including COVID-19, which may be combated, keeping all who work in this high-risk environment, those exposed to saliva and water sprays and blood spatter, safer.11
From the results obtained for the questionnaires and swabs, indication of students' awareness and knowledge related to mobile phone use in a clinical setting was acceptable, but this should not be encouraged while no associated protocol has been developed yet. Moreover, researchers should use the outcomes of this study to develop such a detailed phone use protocol, even its limited use, for both AG and non-AG clinics and for both students and staff. Here, the inclusion of phone coverings to combat the spread of microbes should be stressed and promoted especially when the necessity for its use cannot be ignored. What this study did was create an awareness of behavior related to phone use in these clinics and maybe subconsciously limited its use for the safety of all present. What is required is the formalization of faculty guidelines for mobile phone use within AG and non-AG clinics.
In addition, the consciousness of disinfecting devices, including mobile phones was present and students and staff were implementing these even though none of the COVID 19 protocols was extended to include these mobile phones. Also, the literature and companies have clarified this position and indicated what could be used without damaging the devices.12-15 Results thus showed that participants also tried to implement some of the appropriate actions related to cleansing and disinfecting of mobile phones in the clinical setting. Again, they would probably be more compliant to appropriate actions if formalized evidence-based protocols and guidelines for disinfecting of mobile phones in the dental setting are included in the current Faculty COVID-19 protocols as well.
Both evidence-based guidelines for mobile phone use and a faculty protocol for its disinfection, including compulsory phone coverings can help prohibit transmission of any type of pathogen irrespective what season is experienced. The students and staff are scientists and transmission of infections in different settings is what they know well, as seen with the study outcomes. They would thus not hesitate to adhere to protocols preventing the transmission of germs or microbes during or post the pandemic.
Post this study, the strain of the COVID related virus mutated and the country experienced a 4th wave of the pandemic (with the omicron virus taking center stage). Moreover, many participants who were diagnosed positively with COVID-19 infections also experienced what is called long COVID where patients experienced symptoms for longer than 5 months.21 Swabbing their mobile phones maybe indicate a different set of microbes.21 Therefore, this type of surveillance study is very important as the changes experienced impacted on data collection for the survey and swabbing of mobile phones. Also, not all microbes were tested for yet, thus the microbes from Group C will be determined using polymerase chain reaction (PCR) at a later stage.
CONCLUSIONS
A diverse group of microbes was found on the mobile phones of participants from both aerosol and non-aerosol generating clinics who perhaps do not follow an appropriate and/or regular cleansing and disinfecting protocol. Thus, it would be advisable for the faculty to develop guidelines for mobile phone use in clinics and a standard disinfecting phone protocol as well.
CLINICAL IMPLICATIONS
Mobile phones are regularly used by students and staff in clinics for learning and patient work. These mobile phones are hubs for the growth of microbes and with the COVID-19 pandemic experienced globally and with all the different strains observed, transmission of these may occur which could have been avoided. The guidelines for use of mobile phones in clinics and clinical settings must be very concise and clear to ensure users remain compliant. From the
results, appropriate cleansing protocols after use are also not always adhered to, thus, the guidelines must ensure these are included too. Moreover, regular, and standard disinfecting procedures and media should also be available for mobile phone users. It would also be advisable to expand the institutional COVID-19 protocols to include disinfecting of mobile phones as well.
RECOMMENDATIONS FOR CONTINUING THE STUDY
Gauging from the outcomes and results of this study, surveillance may continue under the following circumstances: temperature changes (winter to summer months); increase in patient treatments/ traffic (due to more students treating more patients/ or at the end of the year when it is quieter when students are away); pandemic conditions (with the 4th and possibly a 5th wave experience or a change or halt of the pandemic) and lastly, different pathotypes of the different microbes that may emerge, including different corona virus strains.
CONFLICT OF INTEREST
The authors declare no conflict of interest
FUNDING
No funding was applied for nor received for the research project.
Research was presented at the IADR-SA, but no funding was requested.
REFERENCES
1. Fedena. What is the impact of mobile device on student learning? Foradian techonologies. 2019. Available from: https://fedena.com/blog/2019/02/what-is-the-impact-of-mobile-device-on-student-learning.html [ Links ]
2. Olsen M, Campos M, Lohning A, et aí., Mobile phones represent a pathway for microbial transmission: A scoping review. Travel Med Infect Dis. 2020 May;35:101704. [ Links ]
3. Panigrahi SK, Pathak VK, Kumar MM, Raj U, P KP. Covid-19 and mobile phone hygiene in healthcare settings. BMJ Glob Health. 2020 Apr;5(4):2505. Available from: /pmc/articles/PMC7204931/ [ Links ]
4. Sánchez Espinoza EP, Farrel MC, Nogueira SV et aí., Are Mobile Phones part of the chain of transmission of SARS-CoV-2 in the hospital? medRx. 2020 Jan;2020.11.02.20224519. Available from: http://medrxiv.org/content/early/2020/11/04/2020.11.02.20224519.abstract [ Links ]
5. Meek A. Touching these 7 things could give you COVID-19. BGR MEDIA, LLC. 2020. p. October 20th. Available from: https://bgr.com/science/coronavirus-transmission-touching-surfaces-risk-of-covid-19/ [ Links ]
6. Kampf G, Todt D, Pfaender S, Steinmann E. Persistence of coronaviruses on inanimate surfaces and their inactivation with biocidal agents. J Hosp Infect. 2020 Mar;104(3):246-51. [ Links ]
7. Dr. Alexis E. Carrington, Dr. Ayodola Adigun. Smartphones and COVID-19 transmission: What we know so far - ABC News. ABC internet Ventures. 202AD. Available from: https://abcnews.go.com/Health/smartphones-covid-19-transmission/story?id=71778492 [ Links ]
8. Marques M, Domingo JL. Contamination of inert surfaces by SARS-CoV-2: Persistence, stability and infectivity. A review. Environ Res. 2021 Feb;193:110559. Available from: /pmc/articles/PMC7706414/ [ Links ]
9. Kathree BA, Khan SB, Ahmed R, Maart R, Layloo N, Asia-Micheals W. COVID-19 and its impact in the dental setting: A scoping review. PLoS One. 2020 Dec;15(12). Available from: https://pubmed.ncbi.nlm.nih.gov/33338073/ [ Links ]
10. CHITLANGE PR. Short Communication: Contamination of cell phones by pathogenic microorganisms: Comparison between hospital staff and college students. Nusant Biosci. 2014 Jan;6(2). Available from: https://smujo.id/nb/article/view/884 [ Links ]
11. R HF, R HF, M M, MA H. Evaluation of the Cell Phone Microbial Contamination in Dental and Engineering Schools: Effect of Antibacterial Spray. J Epidemiol Glob Health. 2018;8(3-4):143-8. Available from: https://pubmed.ncbi.nlm.nih.gov/30864755/ [ Links ]
12. Zoe Moore. How to properly sanitize your cellphone amid coronavirus outbreak | GMA. Good Morning America. 2020. Available from: https://www.goodmorningamerica.com/wellness/story/properly-sanitize-cellphone-amid-coronavirus-outbreak-69535459 [ Links ]
13. How To: Disinfect Your Electronics - COVID-19. For Health. 2020. Available from: https://covid-19.forhealth.org/what-you-can-do/how-to-disinfect-your-electronics/ [ Links ]
14. COVID-19 National Public Hygiene Strategy and Implementation Plan - July 2020 | Department of Health Knowledge Hub. Available from: https://www.knowledgehub.org.za/elibrary/covid-19-national-public-hygiene-strategy-and-implementation-plan-july-2020 [ Links ]
15. DJ W, H K, WA R. 'No touch' technologies for environmental decontamination: focus on ultraviolet devices and hydrogen peroxide systems. Curr Opin Infect Dis. 2016 Aug;29(4):424-31. Available from: https://pubmed.ncbi.nlm.nih.gov/27257798/ [ Links ]
16. Teska P. Portable electronic device management in healthcare. Beckers Healthcare. 2016. Available from: https://www.beckershospitalreview.com/healthcare-information-technology/portable-electronic-device-management-in-healthcare.html [ Links ]
17. Barlean MC, Balcos C, Bobu L, Scutariu MM, Popescu E. Dentists' Compliance To Hands Hygiene As Method of Health Care Associated Infections Prevention. Rom J Oral Rehabil. 2018;10(1):57-63. [ Links ]
18. S D, E R, M G, SR AR, CM Z. Legionella in water samples: how can you interpret the results obtained by quantitative PCR? Mol Cell Probes. 2015 Feb;29(1):7-12. Available from: https://pubmed.ncbi.nlm.nih.gov/25241149/ [ Links ]
19. World Medical Association Declaration of Helsinki: ethical principles for medical research involving human subjects. JAMA. 2013 Nov;310(20):2191-4. Available from: https://pubmed.ncbi.nlm.nih.gov/24141714/ [ Links ]
20. BRION M-JA. Essential Epidemiology: An Introduction for students and health professionals. Penny Webb, Chris Bain, Sandy Pirozzo. Cambridge:Cambridge University Press, 2005. £24.99. ISBN 0521546613. Int J Epidemiol. 2006 Apr;35(2):503-4. Available from: https://academic.oup.com/ije/article/35/2/503/694709 [ Links ]
21. Raveendran AV, Jayadevan R Sashidharan S. Long COVID: An overview. Diabetes and Metabolic Syndrome: Clinical Research and Reviews. 2021 15: 869-75. [ Links ]
 Correspondence:
Correspondence:
Associate Professor Saadika B. Khan
Department of Restorative Dentistry, University of the Western Cape; Private Bag X01, Tygerberg 7505
Tel: +27 21 9373006; E-mail: skhan@uwc.ac.za; ORCID No: 0000-0001-6017-959X
Authorship:
SK: Principal Researcher. Contributed to Protocol, Data collection and Analysis and Manuscript preparation and manuscript finalization (45%)
EM: Contributed to Protocol, Data collection and Analysis and Manuscript preparation and manuscript finalization (25%)
NV: Contributed to Protocol, Data Analysis, Manuscript preparation and finalization (15%)
AT: Contributed to Protocol, Data Analysis, Manuscript preparation and finalization (15%)
Conflict of interest: The authors declare no conflict of interest
Funding: No funding was applied for nor received for the research project. Research was presented at the IADR-SA, but no funding was requested.
Data availability statement:
1. The datasets generated during and/or analysed during the current study are available from the corresponding authors on reasonable request.
2. Data generated or analysed during this study are included in this published article
Acknowledgments: Grateful thanks are extended to the BDS Class of 2021, especially Mr Adnaan Johnson for his contributions. I wish them well in their future careers.
Ethics registration number: BM21/4/7.













